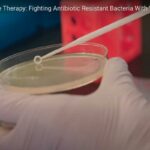
Phage therapy viruses that heal

Salmonella in chicken meat and the potential of bacteriophages Chemical antimicrobials are an industry standard for controlling Salmonella in chicken processing plants, but their effectiveness is declining as the bacteria become increasingly resistant. In addition, these chemicals can also affect the sensory characteristics of the meat. Therefore, there is a growing trend toward alternative methods …
News and events
Bacteriophages: New champion in the fight against Salmonella ?
Bacteriophages and Salmonella Bacteriophages, also known as phages, are viruses that specifically infect bacteria and have been suggested as a potential solution for controlling bacterial infections in humans and animals. Recently, researchers have explored the use of phages as a means of reducing Salmonella infections in poultry, with promising results. In fact, some experts believe …
Bacteriophages: New champion in the fight against Salmonella ?Read More
Bacteriophage Therapy to Reduce Colonization of Campylobacter jejuni in Broiler Chickens before Slaughter
Bacteriophage therapy to reduce colonization of Campylobacter jejuni in Broiler Chickens Did you know that eating contaminated poultry meat is one of the most common ways to become infected with campylobacteriosis, a gastrointestinal disease? This infection is mainly caused by Campylobacter jejuni and is unfortunately common in broiler chickens and difficult to prevent. Fortunately, there …
Isolation, Characterization, and Application in Poultry Products of a Salmonella Specific Bacteriophage, S55
Bacteriophage S55 Salmonellosis, often caused by contaminated food, affects millions of people worldwide each year. This bacterial infection can cause severe gastrointestinal symptoms, making it a serious public health concern. The misuse of antibiotics has increased the prevalence of antibiotic-resistant bacteria, including strains of Salmonella, making prevention and control even more challenging. But there may …
The Virus That Kills Drug-Resistant Superbugs
Phage therapy video Antibiotic-resistant bacteria kill thousands of people every year, the united nations estimate that by 2050, more people will die from antibiotic-resistant infections than currently die from cancer. Discovered 100 years ago, bacteriophages – viruses that eat bacteria – might provide an answer. But phage therapy has only been approved for use on …
The Antibiotic Apocalypse Explained
Antibiotics – video A quick overview on the story of how superbugs “come to life”. Depicting how we, as humanity, created the perfect environment for these beings to exist. This article earlier appeared in the “Kurzgesagt – In a Nutshell ” YouTube channel References are available bellow. https:// www.youtube.com/channel/UCsXVk37bltHxD1rDPwtNM8Q
Is medicine going viral ?
Bacteriophages – video Bacteriophages have been a hot topic in the science community in recent years. This video looks at the structure of bacteriophages, their mode of action and their potential to treat bacterial infections. Alternatives to antibiotics are desperately needed as multidrug resistance in bacteria becomes a more pressing issue This article earlier appeared …
Viruses that heal
Phage Therapy: Fighting Antibiotic Resistant Bacteria With Viruses – video Phages are everywhere. They are found in sewage, wastewater, soil, marine water, animal intestines, and even in the human gut. There are more bacteriophages than any other viruses, and, in fact, they are the most abundant organism on Earth (numbering more than 1031). This makes …
In Vitro and In Vivo Gastrointestinal Survival of Non-Encapsulated and Microencapsulated Salmonella Bacteriophages: Implications for Bacteriophage Therapy in Poultry
In vitro and in vivo gastrointestinal survival of Salmonella bacteriophages – Bacteriophage therapy in poultry The use of bacteriophages as therapeutic agents is gaining momentum in the fight against bacterial infections, and this recent study highlights their potential to combat Salmonella. The researchers found that microencapsulation of the phage in an oral dosage form helped …
The superheroes that we have been waiting for to fight antimicrobial resistance
Bacteriophages video Viruses have a bad reputation, but some of them could one day save your life, says biotech entrepreneur Alexander Belcredi. In this fascinating talk, he introduces us to phages, naturally-occurring viruses that hunt and kill harmful bacteria with deadly precision, and shows how these once-forgotten organisms could provide new hope against the growing …
The superheroes that we have been waiting for to fight antimicrobial resistanceRead More
Bacteriophage cocktail supplementation improves growth performance, gut microbiome and production traits in broiler chickens
Bacteriophage cocktail supplementation – broiler chickens The poultry industry relies heavily on antibiotics for disease control and growth promotion, leading to concerns about the emergence of antibiotic resistance. One potential solution is phage therapy, which uses viruses called phages to target and destroy specific bacterial hosts. A recent study found that adding a phage cocktail …
Bacteriophages: Next generation of smart disinfectants?
Bacteriophages Bacteriophage ticks all the boxes for aquaculture. It has the ability to tackle and eliminate antibiotic resistance range. Being bacteria-specific, it leaves the rest of the microbiota unaffected and intact. It can be used in combinatory schemes for multiple infections at a time. Bacteriophages, also known as phages, are viruses that specifically infect bacteria …
Bacteriophages: Next generation of smart disinfectants?Read More